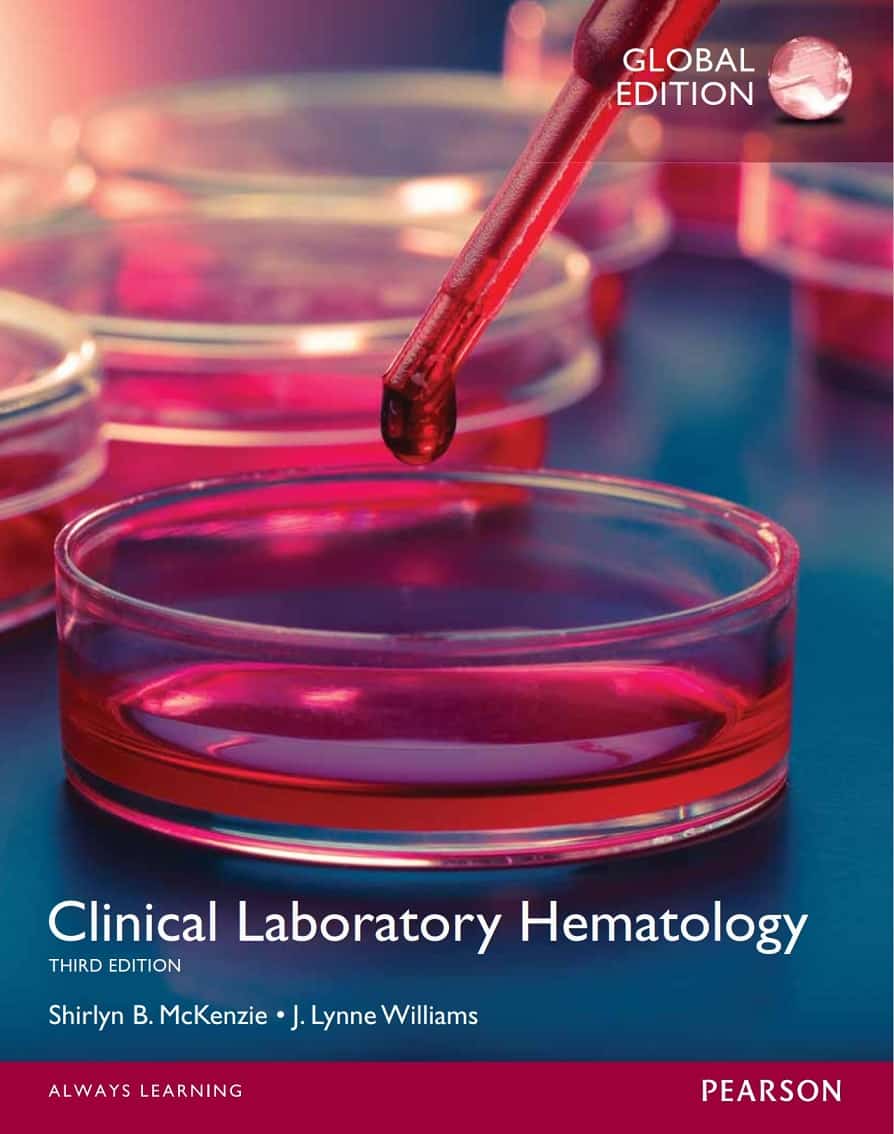

Sale!
Clinical Laboratory Hematology (3rd Global Edition)
$19.99
Download Clinical Laboratory Hematology (3rd Global Edition) written by Shirlyn B. McKenzie, Lynne Williams in PDF format. This book is under the category Medicine and bearing the isbn13 numbers 0133076016; 1292081848/9780133076011/ 9781292081847. You may reffer the table below for additional details of the book. We do NOT provide access codes, we provide eBooks ONLY. Instant access will be granted as soon as you complete the payment. p>
Additional information
| book-author | Lynne Williams, Shirlyn B. McKenzie |
|---|---|
| publisher | Pearson; 3rd Edition (Global) |
| file-type | |
| pages | 1040 pages |
| language | English |
| isbn10 | 0133076016; 1292081848 |
| isbn13 | 9780133076011/9781292081847 |
Related products
- Sale!

Research Methods in Psychology: Evaluating a World of Information (3rd Edition)
$19.99 - Sale!

Cognitive Neuroscience: The Biology of the Mind (5th Edition)
$19.99 - Sale!

Fundamentals of Nursing (3rd Edition) – 2 Volume Set
$19.99 - Sale!

Calculation of Drug Dosages: A Work Text (10th edition)
$19.99